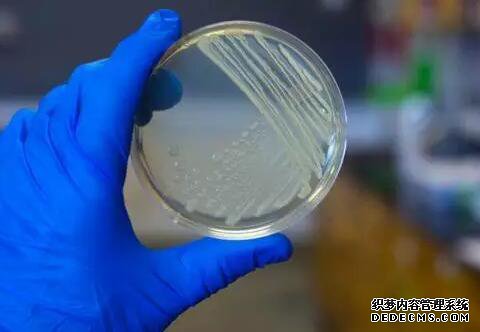

热门文章
随机文章
Eh在微生物中是什么意思?
Eh在微生物中是什么意思?
全部展开
氧化还原电位反应的形式与氧化还原电位,氧化还原电位,氧化还原电位的反应形式无关,所谓的氧化都是电子的损失,因此为了得到所谓的电子而进行的还原必须伴随转移过程。
当将铂电极插入可逆氧化还原AH2A2e2H系统中时,电子将提供给电极,从而导致半电池的电势与系统的降低功率相对应。
通过将其与标准氢电极结合而测得的电势就是系统的氧化还原电势。
氧化还原电势值Eh是氧化的H2的还原自由能(或平衡常数),pH,氧化形式与还原形式的比率[ox]/[red],以及下式:R是气体常数T是绝对温度,F是法拉第常数,n是与系统氧化还原相关的电子数。
如果氧化形式和还原形式相等,则E'为Eh。
pH值为F时的标准电势是系统独特氧化还原能力的指标。
绘制相应的减速率Eh时,E0变成对称的S曲线。
如果Eh相等,Eh high可以氧化Eh low并达到平衡。
但是,这只是热力学中发生的现象。
实际上,尤其是在大多数生物系统中,没有酶或电子介体就不会发生可识别的反应。
氧化还原电势可以直接由该电势确定,并且可以根据平衡常数计算使用氧化还原指数获得。
通常,活体中的电子传输源自氧化还原电势沿降低方向进行的趋势,例如,NAD→黄素酶→细胞色素C→O2。但是,酶的特异性和抑制不是以这种方式进行的。具有低标准电势的系统可能由于反应组分的浓度而氧化较高的系统。
在生物氧化还原系统中,多酚和细胞色素C,a等它们接近200-300 mV,细胞色素b和黄素酶的范围是0-100 mV,在-330 mV的位置,NAD在-420 mV。位置是铁氧化还原蛋白。
在活细胞中,需氧细胞电势高,厌氧电势低,并且酶活性和细胞同化能力以及微生物的生长和发育也受氧化还原电势的影响。

氧化还原电位反应的形式与氧化还原电位,氧化还原电位,氧化还原电位的反应形式无关,所谓的氧化都是电子的损失,因此为了得到所谓的电子而进行的还原必须伴随转移过程。
当将铂电极插入可逆氧化还原AH2A2e2H系统中时,电子将提供给电极,从而导致半电池的电势与系统的降低功率相对应。
通过将其与标准氢电极结合而测得的电势就是系统的氧化还原电势。
氧化还原电势值Eh是氧化的H2的还原自由能(或平衡常数),pH,氧化形式与还原形式的比率[ox]/[red],以及下式:R是气体常数T是绝对温度,F是法拉第常数,n是与系统氧化还原相关的电子数。
如果氧化形式和还原形式相等,则E'为Eh。
pH值为F时的标准电势是系统独特氧化还原能力的指标。
绘制相应的减速率Eh时,E0变成对称的S曲线。
如果Eh相等,Eh high可以氧化Eh low并达到平衡。
但是,这只是热力学中发生的现象。
实际上,尤其是在大多数生物系统中,没有酶或电子介体就不会发生可识别的反应。
氧化还原电势可以直接由该电势确定,并且可以根据平衡常数计算使用氧化还原指数获得。
通常,活体中的电子传输源自氧化还原电势沿降低方向进行的趋势,例如,NAD→黄素酶→细胞色素C→O2。但是,酶的特异性和抑制不是以这种方式进行的。具有低标准电势的系统可能由于反应组分的浓度而氧化较高的系统。
在生物氧化还原系统中,多酚和细胞色素C,a等它们接近200-300 mV,细胞色素b和黄素酶的范围是0-100 mV,在-330 mV的位置,NAD在-420 mV。位置是铁氧化还原蛋白。
在活细胞中,需氧细胞电势高,厌氧电势低,并且酶活性和细胞同化能力以及微生物的生长和发育也受氧化还原电势的影响。